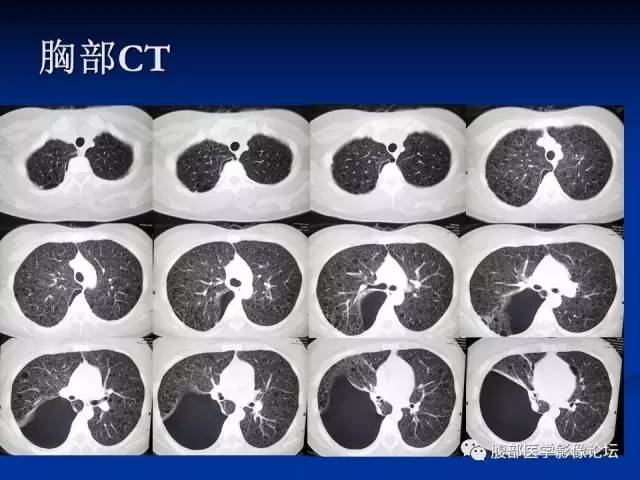
【病例】结节性硬化、肝肾血管平滑肌脂肪瘤、肺淋巴管肌瘤病一例CT

【病例】结节性硬化、肝肾血管平滑肌脂肪瘤、肺淋巴管肌瘤病一例CT
发布时间:2022-10-24
发布时间:2022-10-24

结节性硬化(tuberous sclerosis,TS)又称为Bourneville病,是一种少见的常染色体显性遗传性神经皮肤综合征,多器官系统可见错构瘤或结节,以皮肤、中枢神经系统受累为主,也可有肾脏、视网膜、心脏、肝脏、肺、胃肠及骨骼等全身多个器官系统受累。
皮肤:颜面部的皮脂腺瘤或纤维血管瘤;
CNS:皮层或皮层下结节、室管膜下结节和白质病灶,且发生钙化的概率很高;
腹部:肝、肾错构瘤或多囊肾、直肠错构瘤样息肉;
胸部:肺淋巴管肌瘤病、心脏横纹肌瘤;
其他:视网膜星形细胞瘤或错构瘤、指(趾)甲床多发纤维瘤、骨骼系统异常。








下一篇:【病例】左颞血管周细胞瘤1例MR